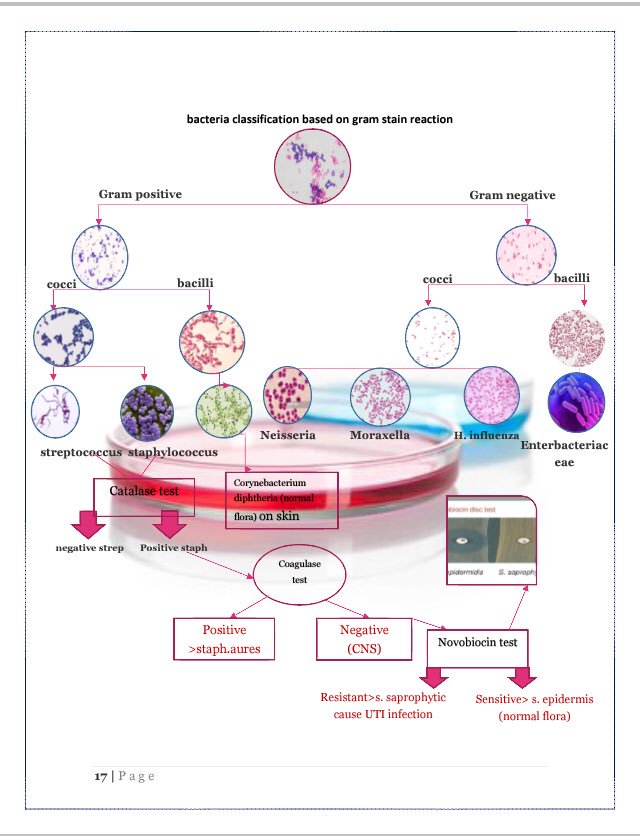

صباح الخير يامختبرجية ☕💙، جبت لكم مجموعة صور مفيدة تنعش ذاكرتكم في عدة مواضيع مختصة باللاب 👍🏻💉🧫🔬🧬
وهنا خطوط الدفاع الثلاثة للجهاز المناعي، مع أجزاء خط كل دفاع، سوو #تفضيل ياطلاب جداً مفيدة 👌♥️
مساء الخير يا 🔬 ، للطلبة الي توهم ياخذون مادة المايكرو في سؤال دايم يحبونه الدكاترة الي هو وش الفرق من ال Flagella و Pili⁉️ فضلوها وشاركوها 🙏💘.
#جمعة_مباركة
#جمعة_مباركة
مساء الخير يا 🔬 كلنا نعرف بشكل عام الاوساط الغذائية في المايكرو ( Media) ذي بعض الانواع المتخصصة او ال Special من نسج وابداع اخوي @Anas_Index 🤍
مساء الخير يا 🔬🤍، الكل يعرف شلة ال (Blot’s) الي نستخدم ال Western منها في الاختبار التأكيدي لل (HIV) هنا الصورة ذي لخصتها بالفروقات كمان واشكال النتائج #فضلوها تحتاجونها أوقات الاختبارات والمقابلات الشخصية ✨🤍🤍
لتفاصيل اكثر الأخت ماقصرت الله يعطيها العافية ✨
مساء الخير يا مختبرجية 🔬🤍، هنا في الشارت الي سواه الرهيب @Anas_Index يعطيك انواع العينات في لاب الميكرو ياطلاب وأخصائي المختبر تفيدكم في الاختبارات والمقابلات الشخصية 🔂🔂🔥
جاري تحميل الاقتراحات...